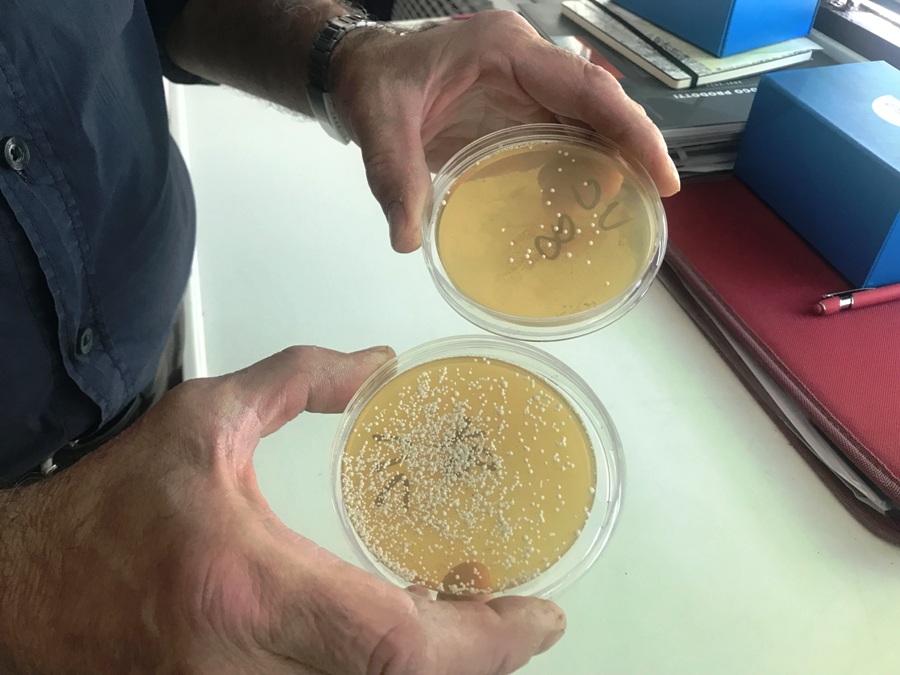

SAN CASCIANO – Gianfrancesco Paoletti ha 60 anni. E’ uno degli enologi chiantigiani con maggiore esperienza in assoluto.
Si è formato con uno dei più grandi a livello mondiale, uno dei padri dell’enologia moderna: quel Giacomo Tachis che a poche centinaia di metri dal laboratorio di analisi di Paoletti (in via Argiano 27, a San Casciano Val di Pesa) viveva e lavorava.
In quelle Cantine Antinori che, nella loro vecchia sede di via Empolese, sono state a lungo anche il luogo di lavoro dello stesso Paoletti.
Lo andiamo a trovare proprio nel suo laboratorio d’analisi, allestito ormai da oltre venticinque anni: un vero e proprio punto di riferimento nel territorio del Chianti fiorentino per le analisi enologiche.
“Sono uscito dalla scuola a luglio del 1981 – ci racconta Paoletti – con un diploma di perito agrario. E mi sono iscritto alla Facoltà di Agraria di Firenze nel settembre di quell’anno. Contemporaneamente però, Giacomo Tachis mi chiese di andare a lavorare da Antinori. “A me – disse Tachis – non importa tu faccia l’università ma mi basta che tu studi”. Non ho continuato l’Università e ho fatto tutto un percorso con lui. Partendo, come si faceva una volta, dalla gavetta”.
Parlando di Giacomo Tachis parliamo, come detto, di uno dei padri dell’enologia moderna a livello mondiale: Paoletti è cresciuto a quella “scuola”, e poi vi ha lavorato a lungo. Fianco a fianco.
“Mi sono specializzato molto andando in giro per l’Italia – continua nel suo racconto – E visto che soprattutto alla fattoria di Santa Cristina (le odierne Tenute Tignanello) mancavano gli enologi, facevo molto la spola fra San Casciano (dove c’erano le Cantine Antinori) e Montefiridolfi (alla fattoria)”.
Dopo oltre 15 anni, nel 1997, la decisione: “Ho lasciato Antinori per dedicarmi alla libera professione, anche spinto dallo stesso Tachis, che aveva bisogno di una persona affidabile per le analisi a 360 gradi. Aveva bisogno di un aiuto esterno, in particolare dal punto di vista analitico per le sue consulenze in giro per l’Italia”.
“Lavoravamo molto in Toscana, Sardegna, Sicilia – racconta ancora Paoletti – Fra gli altri, sui vini di Tenuta San Guido, Castello di Rampolla, Querciabella, Argiano a Montalcino, Cantina Sociale Santadi e Argiolas in Sardegna, Donnafugata e Istituto della vite e del vino in Sicilia”.
Una professionalità rara quella di Paoletti, che unisce le competenze enologiche a quelle analitiche: “Il supporto analitico all’enologo (o al cantiniere) è la mia specializzazione. In più, essendo enologo (ho tuttora consulenze, soprattutto in Toscana e Umbria) eseguo una valutazione enologica dell’analisi. Analisi che, tengo sempre a specificarlo, sono effettuate solo da me, in prima persona”.
Parliamo, sottolinea ancora, di analisi enologiche “molto artigianali nel senso buono del termine, con tutti i supporti tecnologici del caso. Diciamo che io sono la bottega, con la differenza che riesco a fare i prezzi da supermercato. Le tariffe sono infatti in linea con i prezzi di mercato”.
Ci sono altre peculiarità che rendono questo laboratorio di analisi, nel cuore della campagna sancascianese, un punto di riferimento.
Possibilità di consegna campioni sette giorni su sette, anche festivi, flessibilità di orario, disponibilità al ritiro dei campioni direttamente in azienda nel territorio sancascianese.
“Ci tengo molto – conclude – a collaborare maggiormente con aziende del territorio sancascianese e della zona del Chianti fiorentino: sia per la vicinanza al laboratorio, sia perché qui sono nate il mio amore e la mia passione per il vino”.

Contatti
📍 Via Argiano 27, San Casciano in Val di Pesa (FI)
📞 055820093
📱 3687058993
📨 gianfrancesco.paoletti@gmail.com
(CONTENUTO SPONSORIZZATO)
©RIPRODUZIONE RISERVATA